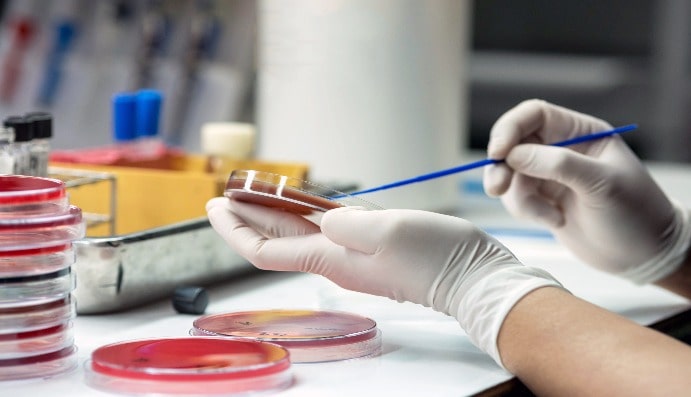

Bakterial Endotoksinin (LAL) Təyini DEVAMINI OKU

BLOG
Bakterial Endotoksinin (LAL) Təyini DEVAMINI OKU

TS EN 14683 Tibbi üz maskaları - Tələblər və sınaq üsulları DEVAMINI OKU

Steril Testlər DEVAMINI OKU

Üzvi Pambığın Faydaları DEVAMINI OKU

Üzvi Pambıq Təhlili DEVAMINI OKU

GOTS Sertifikatı DEVAMINI OKU